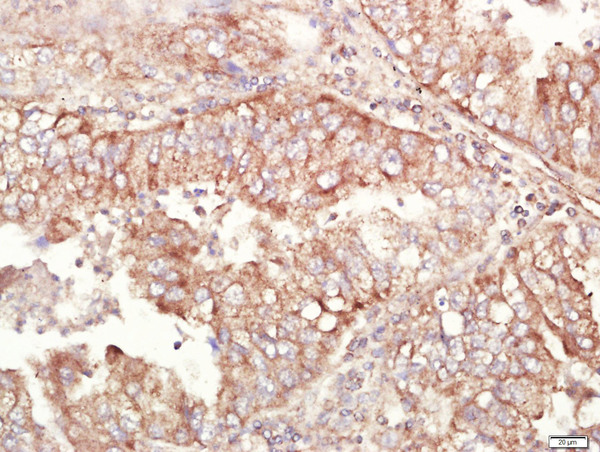

Image obtained from One World Lab validations program. A549 cells were stained with ALDH1 Polyclonal Antibody, Unconjugated (bs-10162R) at 1:50 in PBS and incubated for one hour at room temperature, followed by secondary antibody incubation, DAPI staining of the nuclei and detection.
ALDH1A1 Polyclonal Antibody
BS-10162R
ApplicationsFlow Cytometry, ImmunoFluorescence, Western Blot, ELISA, ImmunoCytoChemistry, ImmunoHistoChemistry, ImmunoHistoChemistry Frozen, ImmunoHistoChemistry Paraffin
Product group Antibodies
ReactivityBovine, Equine, Human, Mouse, Porcine, Rabbit, Rat, Sheep
TargetALDH1A1
Overview
- SupplierBioss
- Product NameALDH1A1 Polyclonal Antibody
- Delivery Days Customer16
- ApplicationsFlow Cytometry, ImmunoFluorescence, Western Blot, ELISA, ImmunoCytoChemistry, ImmunoHistoChemistry, ImmunoHistoChemistry Frozen, ImmunoHistoChemistry Paraffin
- Applications SupplierWB(1:300-5000), ELISA(1:500-1000), FCM(1:20-100), IHC-P(1:200-400), IHC-F(1:100-500), IF(IHC-P)(1:50-200), IF(IHC-F)(1:50-200), IF(ICC)(1:50-200)
- CertificationResearch Use Only
- ClonalityPolyclonal
- Concentration1 ug/ul
- ConjugateUnconjugated
- Gene ID216
- Target nameALDH1A1
- Target descriptionaldehyde dehydrogenase 1 family member A1
- Target synonymsALDC, ALDH-E1, ALDH1, ALDH11, HEL-9, HEL-S-53e, HEL12, PUMB1, RALDH1, aldehyde dehydrogenase 1A1, 3-deoxyglucosone dehydrogenase, ALDH class 1, ALHDII, RALDH 1, acetaldehyde dehydrogenase 1, aldehyde dehydrogenase 1, soluble, aldehyde dehydrogenase, liver cytosolic, epididymis luminal protein 12, epididymis luminal protein 9, epididymis secretory sperm binding protein Li 53e, retinal dehydrogenase 1, retinaldehyde dehydrogenase 1
- HostRabbit
- IsotypeIgG
- Protein IDP00352
- Protein NameAldehyde dehydrogenase 1A1
- ReactivityBovine, Equine, Human, Mouse, Porcine, Rabbit, Rat, Sheep
- Storage Instruction-20°C
- UNSPSC41116161
References
- Sorting and identification of side population cells in the human cervical cancer cell line HeLa. Qi W et al., 2014 Jan 13, Cancer Cell IntRead this paper